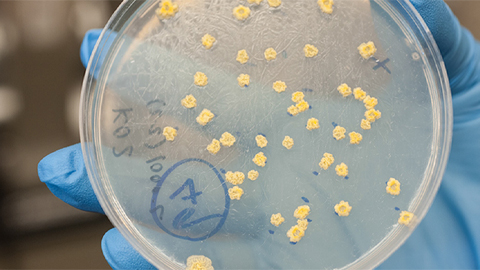
Can membrane stress protect mycobacteria?

Contributors
Anna Hu

Anna Hu earned her bachelor's degree in biochemistry from Wellesley College and is now a research assistant at the Harvard School of Public Health. She is a volunteer writer for ASBMB Today.
Articles by Anna Hu

Interview
Meet Paul Shapiro
April 29, 2025
Learn how the JBC associate editor went from milking cows on a dairy farm to analyzing kinases in the lab.

ASBMB Annual Meeting
Host vs. pathogen and the molecular arms race
March 28, 2025
Learn about the ASBMB 2025 symposium on host–pathogen interactions, to be held Sunday, April 13 at 1:50 p.m.

Award
What seems dead may not be dead
Dec. 4, 2024
Vincent Tagliabracci will receive the Earl and Thressa Stadtman Distinguished Scientist Award at the ASBMB Annual Meeting, April 12–15 in Chicago.

Research Spotlight
A scientist's journey through disability, grad school, and beyond
Nov. 7, 2024
By the end of high school, Crystal Mendoza already had lab experience and was well on her way to a college degree and a promising future. All the bumps in her road lay ahead.

Profile
There and back again: A Barbadian biochemist’s tale
Oct. 9, 2024
Shane Austin’s linear academic journey to a Ph.D. focused on the study of mitochondria took him many thousands of miles from his island home.

Annual Meeting
For Wolfson, every classroom is a laboratory
Nov. 9, 2023
She won the 2024 ASBMB Sustained Leadership Award.

Journal News
From the journals: MCP
Aug. 11, 2023
A mid-life crisis in the eye. An alternate approach to finding alternative proteins. A better way to process LC mass spec. Read about recent papers on these topics.

Pride
A space for LGBTQIA+ grad students to be their best
July 5, 2023
Once organizers started the group that became oSTEM at UT Southwestern, they found a community that was willing and excited to show up.

Journal News
From the journals: MCP
June 20, 2023
How Alzheimer’s affects brain glycosylation. Reducing false positives in mass spectrometry. With O-glycopeptides, two methods are better than one. Read about recent papers on these topics.

Student Chapters
'ASBMB opened the doors for me'
March 30, 2023
Membership in the New Mexico State Student Chapter led Clarissa Nuñez to consider a career in science. Now she’s a Ph.D. student at UT Southwestern.
Journal News
Can membrane stress protect mycobacteria?
Nov. 22, 2022
While working on an unrelated project, researchers noticed that membrane fluidization led two membrane glycolipids called PIMs to undergo acylation.

In Memoriam
In memoriam: Ludwig Brand
July 11, 2022
He was a longtime professor of biology at the Johns Hopkins University Krieger School and a member of the ASBMB for more than 50 years.

Journal News
From the journals: JLR
Dec. 9, 2021
New lipid markers of liver disease. Leptin landmarks and obesity genetics. How fatty acid versatility extends to Type 2 diabetes. Read about papers on these topics recently published in the Journal of Lipid Research.